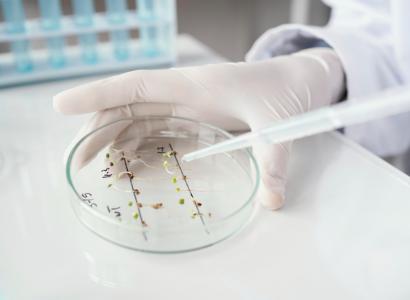
Путину представили проект генетического дизайна сельхозкультур

Новости
04.02.2026
03.02.2026
02.02.2026
30.01.2026
30.01.2026
29.01.2026
28.01.2026
26.01.2026
26.01.2026
22.01.2026
20.01.2026
19.01.2026
16.01.2026
15.01.2026
14.01.2026
13.01.2026
12.01.2026
30.12.2025
29.12.2025
25.12.2025
24.12.2025
23.12.2025
22.12.2025